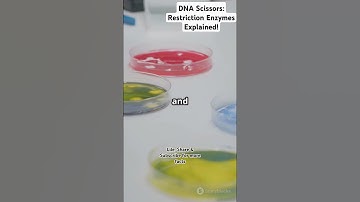
DNA Scissors: Restriction Enzymes Explained! #facts #science #botany #biology #restrictionenzymes

⬇ DOWNLOAD NOW
Kalau muncul iklan pop-up, tutup lalu klik tombol kembali
Download lagu What Are Restriction Enzymes? The Molecular Scissors of DNA 🔬✂️ #bioinformatics #redditstories secara gratis hanya untuk keperluan promosi. Dukung artis favorit kamu dengan membeli musik original di iTunes atau platform resmi lainnya.
 Restriction Enzymes Explained: The Molecular Scissors of DNA 🔬✂️
Restriction Enzymes Explained: The Molecular Scissors of DNA 🔬✂️
 Restriction Enzymes
Restriction Enzymes
 “Restriction Enzymes: Molecular Scissors of Biotechnology”
“Restriction Enzymes: Molecular Scissors of Biotechnology”
 CRISPR Explained
CRISPR Explained
DNA Scissors: Restriction Enzymes Explained! #facts #science #botany #biology #restrictionenzymes
DNA Scissors: Restriction Enzymes Explained! #facts #science #botany #biology #restrictionenzymes
 Restriction Enzymes Explained | How Molecular Scissors Work!
Restriction Enzymes Explained | How Molecular Scissors Work!
 Restriction Enzymes: Unleashing the Molecular Scissors
Restriction Enzymes: Unleashing the Molecular Scissors
 Restriction Endonuclease Animation: Types || Mechanism || Nomenclature
Restriction Endonuclease Animation: Types || Mechanism || Nomenclature